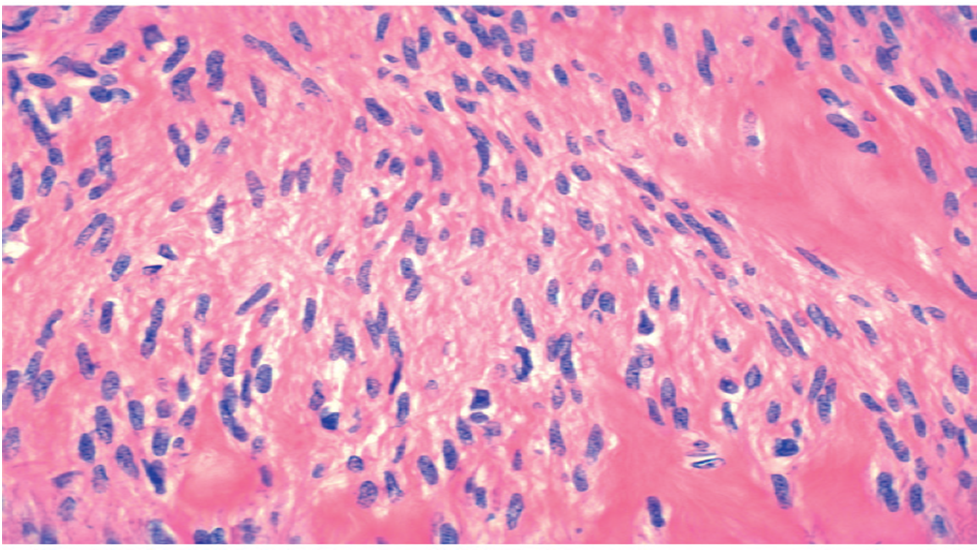

Leiomyoma of uterus
Gross description-A specimen show leiomyoma are typically sharply circumscribed, firm gray-white masses with a characteristic whorled cut surface.
Microscopic description-On histologic examination, the tumors are characterized by interlacing bundles of smooth muscle cells mimicking the appearance of normal myometrium. 
Endometrial stromal sarcoma
Gross description: A specimen of uterus with cervix total measuring (15x13) cm. On Cut surface show yellowish whitish large mass identified involving fundus, body, lower uterine segment measuring 14x9 seen.
Microscopic description-The sections show are composed of uniform, predominantly oval, small cells, very closely resembling those of the endometrial stroma. Tumor is composed of bland oval nuclei arranged around concentrically round spiral arterioles. Mitotic activity seen.
Leimyoma of uterus
Gross description:A specimen show intramural leiomyomas are typically sharply circumscribed, firm gray-white masses with a characteristic whorled cut surface.
Microscopic description-On histologic examination, the tumors are characterized by bundles of smooth muscle cells mimicking the appearance of normal myometrium.
Leimyoma of uterus
Gross description: A specimen show intramural leiomyomas which is sharply circumscribed, firm gray-white masses with a characteristic whorled cut surface.
Microscopic description-On histologic examination, the tumors are characterized by bundles of smooth muscle cells mimicking the appearance of normal myometrium.

